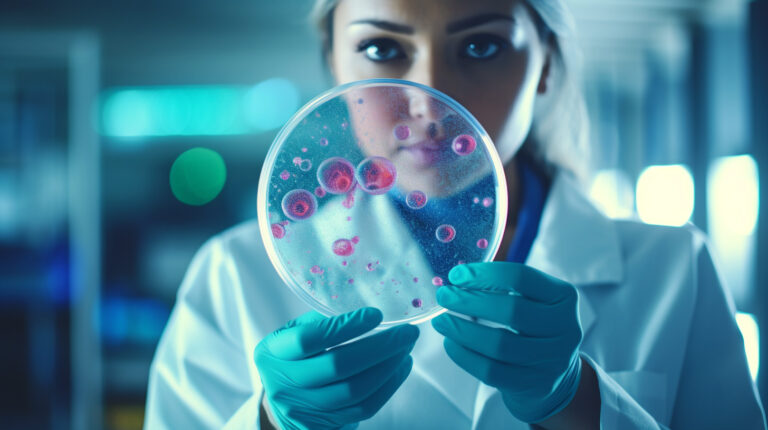

iSpecimen Inc. (NASDAQ:ISPC) Q3 2023 Earnings Call Transcript November 3, 2023
Operator: Good day, everyone, and welcome to iSpecimens Third Quarter 2020 Results Conference Call. At this time, participants are in listen-only mode. Question-and-answer session will follow management’s remarks. This conference call is being recorded. A replay of today’s call will be available on the Investor Relations section of iSpecimens website and will remain posted for the next 30 days. I will now hand the call over to Phil Carlson, Investor Relations for introductions and the reading of the safe harbor statement. Please go ahead.
Phil Carlson: Thank you, operator. Good morning, everyone, and welcome to iSpecimen’s third quarter 2023 results conference call. With us on today’s call is Tracy Curley, Chief Executive Officer; Benjamin Bielak, Chief Information Officer; Eric Langlois, Chief Revenue Officer; and Carly Lejnieks, Vice President of Marketing. Before we begin, I would like to remind you that today’s call contains certain forward-looking statements from our management made within the meaning of Section 27A of the Securities Act of 1933 as amended and Section 21 of the Securities and Exchange Act of 1934 as amending concerning future events. Words such as may, should, projects, expects, intends, plans, believes, anticipates, hopes, estimates and variations of such words and similar expressions are intended to identify forward-looking statements.
These statements are subject to numerous conditions, many of which are beyond the control of the company, including those set forth in the Risk Factors section of the company’s Form 10-K for the year ended December 31, 2022, filed with the SEC. Copies of this document are available on the SEC’s website at www.sec.gov. Actual results may differ materially from those expressed or implied by such forward-looking statements. The company undertakes no obligation to update these statements for revisions or changes after the date of this call, except as required by law. Now it’s my pleasure to introduce Tracy Curley, Chief Executive Officer. Tracy, please go ahead.
Tracy Curley: Good morning, and thank you for joining our call today. I’d like to take this opportunity to discuss how our recent initiatives to rightsize our business and enhance our operational structure and processes are paving the way for a new stage of future growth for iSpecimen. I will then turn the call over to Eric Langlois, our Chief Revenue Officer; Carly Lejnieks, our Vice President of Marketing; and Benjamin Bielak, our Chief Information Officer. Each will detail activities related to their operational responsibilities within iSpecimen. Finally, I will review our financial performance for the 3 and 9 months ended September 30, 2023, and open the call for questions. Since the first of this year, our team has advanced several new initiatives to allow us to operate more efficiently and effectively.
I can say with a high degree of certainty that iSpecimen is not the same company today than we were at the beginning of this year. Every facet of how the company is operating and engaging internally and externally with our customers and supplier organizations has been reviewed and were needed improved upon. Throughout the year and culminating with a reduction in force the first week of September, we have been driving towards rightsizing the company. On September 6, we reduced our total workforce by approximately 20%. As a result of this initiative, including employee turnover during the year, the monthly expenses related to head count are expected to decrease by approximately 29% for the remainder of the year compared to the average monthly cost for the first 9 months of the year.
We also made additional expenditure reductions after streamlining operations and rationalizing resources to focus on key market opportunities. All other monthly operational costs are expected to decrease by approximately 52% for the remainder of the year compared to the average monthly cost for the first 9 months of the year. We completed the implementation of our next-day quote program in the third quarter of 2023. This solution has transformed the way we interact with our customers and supplier networks and has significantly reduced the time between opportunity to quote and by extension, the time between issuing the quote and receiving the purchase order. After implementing its program, we recognized a conversion increase of 122% for the quotes to purchase orders for the third quarter of 2023 compared to the blended quarterly average of the prior 4 quarters, demonstrating the positive impact of this program.
Moving to the supplier side of our business. We have dedicated significant resources to expanding our global provider network in a more purposeful and strategic manner. We are especially focused on quality over quantity as it pertains to our supplier network with the goal of building and expanding our supplier relationships with our most active and reliable revenue generators. At the beginning of the third quarter, we announced the addition of 13 new suppliers to our provider network, which collectively expanded iSpecimen’s ability to fulfill requests in high-demand specimens within cancer and hematology, cardiovascular, autoimmune, neurological, endocrine, metabolic and infectious disease categories, among others. The expansion of our network also enables us to gain access to a new collection of biospecimens from diverse patient populations.
We further expanded our provider network in the third quarter to help advance women’s health research, increasing the availability of high-quality tissue and biofluid specimens for studies on cervical, uterine and breast cancer, reproductive health, cardiovascular disease and sexually transmitted infections. While our expansion efforts have increased the strength of our supplier network, we are working behind the scenes reviewing our existing supplier network. And in the fourth quarter this year, we will be winding down relationships with certain suppliers that no longer meet our needs or the needs of our researchers. While this will sharply decrease our supplier network, we expect these efforts to meaningfully strengthen our specimen capabilities and drive both near and long-term revenue opportunities for iSpecimen and for our supplier partners.
In the third quarter of 2023, we rolled out two revenue-enhancing projects, a sequencing procurement program and our embedded coordinator program. Eric will speak to both of these projects in more detail. First, I would like to highlight the tremendous potential of our sequencing procurement program, which we launched at the end of August. The launch of this program is extremely timely as we are seeing increased demand from cancer researchers for DNA, RNA and biomarker sequence data from donor mutation characterized FSP blocks [ph] tumor tissue. Our specimen has created what we believe is the industry’s largest exclusive inventory of cancer sequence specimens to enable critical access to mutation characterized tissue and adjacent sessions needed to help advance cancer research.
There is currently a shortage of mutation characterized FFPE tissue available for researchers, and we believe iSpecimen is strongly positioned to play an integral role in serving the high-growth market, which is expected to reach $2.75 billion by 2031, according to transparency market research. I’d also like to touch briefly on the embedded coordinator project. As we mentioned on our call last quarter, this project is intent to provide on-site dedicated resources to our best and most potentially impactful sites, thus enabling them to fulfill requests at a significantly higher level. And in the process, we expect this to result in additional revenue. Our original plan was to have 12 embedded coordinators in place at supplier sites by the end of the second quarter.
However, as this project got underway, we learned a great deal about the unique needs of our supplier organization. We made a conscious decision to slow the pace for embedding coordinators, creating a pilot program instead in order to take the time to ensure the success of this program. To date, four large supplier sites have been chosen. These supplier sites are working on fulfilling orders and other projects exclusively for iSpecimen. The program will be evaluated quarterly with plans to expand and we see expected revenue growth from these embedded coordinator sites. I will now like to turn the call over to Eric Langlois, Chief Revenue Officer, to provide an update on the key adjacent revenue opportunities introduced earlier this year. Eric?
Eric Langlois: Thank you, Tracy. Good morning, everyone. I’d first like to touch on the embedded coordinator project. As Stacy mentioned, this project is intended to provide resources to what we believe are our best and most potentially impactful sites and enable them to generate additional revenue. Most of these clinical sites lock the bandwidth to manage the day-to-day operations, much less fulfill iSpecimen customer orders, which have historically received reduced priority. As already mentioned, 4 large supply sites have been chosen to be part of our pilot program. Embedded coordinators will be employed by the supplier, but will receive training and support from iSpecimen. Strategic growth plans have been established for all participating sites.
These resources have already proven useful to our next-day quote program as well as to increased fulfillment for our remnant, bank and prospective product lines. We look forward to continued improvements, increased efficiency and revenue growth from the initial and future planned embedded coordinator sites. For sequencing, we placed a significant emphasis on launching our sequencing procurement program this year, with much of the progress occurring in the most recent quarter. This program will not be possible without the breadth, depth and great support of partners from our supplier network. It’s truly been a collaborative effort aimed at helping solve a major bottleneck in cancer research. Cancer based genomic biomarkers have become an integral part of therapeutic research for immuno-oncology drugs as well as in the area of precision medicine in the form of companion diagnostic tests.
These characterized tissues also serve a major role for our general life science customers, making various assays, tests, techniques and capital equipment aimed at addressing the same market. As this is now public knowledge, I want to extend a special thanks to Azenta GENEWIZ, our current commercial sequencing partner who’s processed and run all of our tumor samples to date. We now believe we’ve amassed the world’s largest commercially available single-access collection of fully next-generation sequence cancer cases using Illumina’s AmpliSeq comprehensive cancer panel version 3. We’re approaching 1,500 exclusive cases in the program across various tumor types such as colon cancer, lung cancer, breast cancer, ovarian cancer, pancreatic cancer, head and neck cancer, prostate cancer, bladder cancer, renal cancer, brain cancer and melanoma.
These samples have been analyzed for both DNA and RNA sequencing. We’ve embarked on a massive multipronged marketing and sales campaign that Carly Lejnieks will speak to shortly to generate demand for all of these characterized cases. iSpecimen is already processed and shipped several orders and has built out a pipeline of 20 to 30 projects. We’re in the process of reaching out to tens of thousands of contacts in the world of cancer research and are quite bullish that the program will be a success. There’s more to come as we get deeper into the program and the marketing effort throughout the fourth quarter. Now I’ll turn the call over to Carly to provide a more detailed discussion of our multipronged marketing strategy. Carly?
Carly Lejnieks: Thank you, Eric, and good morning, everyone. The marketing launch of our sequence sample offerings is focused on a multichannel multipronged approach that includes targeted outreach to a growing volume of new and existing accounts in the cancer research and cancer genomic space. We have also implemented a cost-effective digital strategy that is working 24/7 to drive awareness, demand and inbound lead generation from an expanded global target audience. To accelerate the creation of new connections in this new market segment, we are also attending key conferences, beginning with the American Society of Human Genomics, which is underway as we speak. We are confident that integrating database marketing, co-prospecting, a digital inbound strategy and face-to-face conference activities will broaden our reach and increase impact in the shortest period of time.
I would now like to turn the call over to Ben Bielak, who will speak regarding our iSpecimen marketplace platform and how greater efficiencies are supporting new opportunities to scale the platform. Ben?
Benjamin Bielak: Thank you, Karl, and good morning, everyone. Our product and technology efforts to improve the iSpecimen marketplace platform in 2023 include updating search functionality, improving the user interface, increasing automation and enhancing matchmaking. While we continue to move the product road map forward, we made the difficult decision earlier this quarter given the results in Q2 to moderate our development acceleration. This decision does not reflect any change in direction. If anything, these changes have enhanced our exploration of options like 5 versus build strategies. The team continues to work to support immediate business needs and realizing additional value from the investments over the last year. iSpecimen continues to focus on innovative ways to strengthen the iSpecimen platform for our network of researchers and providers.
We are delivering on areas such as supporting our newly announced cancer sequencing procurement program, improving the integration with our provider partners, driving improved data quality and matchmaking, including leveraging external content providers and increasing operational efficiency. Further, we are continuing to update our back-end architecture to support growth and scale, enhance security and prepare for our data service pilot, which is slated to take place in 2024. The current phase of these back-end updates is expected to be completed by the end of 2023. We believe the successful completion of the data of the service pilot will allow us to validate one of many possible additional revenue streams for the company. I’ll now turn the call back to Tracy to provide a more detailed discussion of our financial results for the third quarter of 2023 compared to the same period of 2022.
Tracy?
Tracy Curley: Thanks, Ben. Turning to our results. For the third quarter of 2023, we reported $2.8 million in revenue compared to $2.6 million in the third quarter of 2022 and $1.6 million in the second quarter of 2023, respectively. The current 3-month period compared to the same period last year and the second quarter of 2023 increased by $195,000 or 8% and $1.2 million or 75%, respectively. The increase in revenue in the third quarter of 2023 compared to the same period last year was primarily attributable to an increase of 527 specimens or 11% in specimen account from 4,840 specimens and the 3 months ended September 30, 2022 to 5,367 specimens in the 3 months ended September 30, 2023. The effect of the increase in specimen count was partially offset by a change in the specimen mix, which caused the average selling price per segment to decrease by $16 per specimen or 3% from $534 per specimen in the 3 months ended September 30, 2022, to $518 per settlement in the 3 months ended September 30, 2023.
During the 9-month period ended September 30, 2023, we reported revenue of $7.35 million compared to $7.44 million during the same period last year. The slight decrease in revenue for the 9-month period ended September 30, 2023, was primarily attributable to a decrease in average selling price per specimen of $50 or 11% from $444 per specimen in the 9 months ended September 30, 2022, to $394 per specimen in the 9 months ended September 30, 2023. The decrease in average selling price per specimen was offset by an increase of 1,910 specimens or 11% in specimen count from 16,768 specimens in the 9 months ended September 30, 2022, to 18,678 specimens in the 9 months ended September 30, 2023. Cost of revenue increased by $211,000 or 18% from $1.2 million for the 3 months ended September 30, 2022 to $1.4 million for the 3 months ended September 30, 2023 versus was attributable to a $15 per specimen or a 6% increase in the average cost per specimen and an 11% increase in the number of specimens a session for the current period compared to the same period in the prior year.
Cost of revenue for the 9-month period ended September 30, 2020 [ph] was $3.39 million compared to $3.35 million for the same period in 2022. This increase was attributable to an 11% increase in the number of specimens of session during the 9 months ended September 30, 2023, over the same period in the prior year, which was offset by an $18 per specimen or a 9% decrease in the average cost per specimen impacted by the spectrum mix during the 9-month period ended September 30, 2023, over the same period in 2022. For the third quarter of 2023, we reduced our cash spend for technology to $1.19 million from $1.23 million for the same period in the prior year. The cash outlay was comprised of $770,000 of capitalized internally developed software and $427,000 of technology expenses that we were not able to capitalize and therefore, reclassify this technology expenses.
The remainder of the technology expense for the third quarter of 2023 was comprised of $494,000 of noncash amortization related to internally developed software. Total technology expenses for the third quarter of 2023 were $922,000 compared to $753,000 for the same period in the prior year. For the 9-month period ended September 30, 2023, we increased our cash spend for technology to $4.7 million from $2.6 million for the same period in the prior year. This cash at let was comprised of $3.5 million of capitalized internally developed software and $1.2 million of technology expenses that we were not able to capitalize and therefore, reclassify this technology expenses. The remainder of the technology expense for the first 9 months of 2023 was comprised of $1.4 million of noncash amortization related to internally developed software.
Total technology expenses for the first 9 months of 2023 were $2.6 million compared to $1.9 million in the same period in the prior year. The increase in expense for the 9-month period ended September 30, 2023, compared to the same prior year’s period is directly related to our plan of increasing our investment in technology in the first half of 2023, which is manage the continued advancement of our transformational online biospecimen marketplace. Sales and marketing expenses were $898,000 for the third quarter of 2023 compared to $833,000 for the third quarter of 2022. The increase was attributable to increases in professional fees of $123,000 and payroll and related expenses of $112,000 due to hiring more sales personnel, which were partially offset by decreases in external marketing expenses of $169,000.
For the 9-month period ended September 30, 2023, and sales and marketing expenses were $2.97 million compared to $2.53 million during the same period in the prior year. The period-over-period increase was primarily attributable to increases in payroll and related expenses of $535,000, external marketing expenses of $271,000 in general operating expenses related to sales and marketing of $17,000, which were partially offset by a decrease in advertising and promotion expense of $381,000. General and administrative expenses for the 3 months ended September 30, 2023, decreased by $1.13 million or 51% to $1.11 million compared to $2.24 million for the same period last year. For the 9-month period, general and administrative expenses decreased by $1.1 million or 20% and from $5.6 million for the 9 months ended September 30, 2022, to $4.5 million for the 9 months ended September 30, 2023.
Through the 9 months of 2023, the company had a cash burn of $9.7 million, primarily comprised of $6.2 million for operating expenses and a $3.5 million of capitalization to further develop the iSpecimen marketplace technology with plans to invest at a lower level for the remainder of the year. As of September 30, 2023, iSpecimen had $2.7 million of cash and cash equivalents and $2.9 million of available-for-sale securities with maturities ranging from 1 to 6 months for compliant total of $5.6 million compared to a cash balance of $15.3 million as of December 31, 2022. This concludes our prepared remarks. Now I’d like to open the call for questions. Operator, please go ahead.
Operator: Thank you. We will now begin the question-and-answer session. [Operator Instructions] Our first question comes from the line of Matt Hewitt at Craig Hallum. Please go ahead. Your line is open.
See also Guns per Capita by Country Vs Crime Rate: Top 20 Countries and 12 Best Aerospace and Defense Stocks to Buy.
Q&A Session
Follow Ispecimen Inc. (NASDAQ:ISPC)
Follow Ispecimen Inc. (NASDAQ:ISPC)
Receive real-time insider trading and news alerts
Matt Hewitt: Good morning and congratulations on the strong quarter. Thank you for taking the questions. Maybe first up, what has been the feedback from customers? I realize it’s very early days on the sequencing service, but what has been the early feedback? And then what has you most excited about that program as you start to look into not only this quarter, Q4 but into fiscal ’24??
Tracy Curley: Thanks, Matt, for the question. It’s a good question. I’m actually going to defer to Eric who’s on the front lines talking with our customers about this, so it’s been pretty exciting. Eric, would you like to answer the question, please?
Eric Langlois: Sure. Yes. Thanks for the question, Matt. I’d say that [indiscernible] the most excited is just that one of the major initiatives we’ve done over the last couple of weeks is look back over the last year to 18 months of requests that came in for mutation characterized material and kind of reach back out to those people to get awareness that we’ve done this and show them we actually matched up specific cases that we had case results that match the original request. And we’ve received an overwhelming response rate from those customers. I mean it’s nearing about 75% to 100% response rate. Majority of those customers still have those needs. They haven’t been able to actually fill those needs. So that was one of the most recent signals.
But what we’re seeing is that people are definitely not finding avenues to fulfill these projects. I think where we are in the calendar year, people have been at this for a while, so they’re filling some specific niche buckets. But the response rates, the open rates, the interest in the program and then the consistent reach out to us by the sequencing companies and companies that are offering these kind of services, telling us that it’s a great program to do that they’d like to be a part of. They might want to offer up sequencing services has all been really interesting. So to your point, it is early days. In the beginning, we were really hunting for preorders and trying to get things lined up from once we started the runs. But now that we have the runs and we have case data, everything has been overwhelmingly positive about what we’re doing and the direction we’re going, the cancers that we’ve selected, the profiles that we selected, all of that has been really positive.
So right now, it’s just all about the blocking and tackling of trying to match up to the actual open requests that people are looking for right now.
Matt Hewitt: That’s helpful.
Tracy Curley: This is a program which is an that we started January 1 after some significant research on where there was a deficit in the market to fill the need. And so you tailored this program to that deficit that our research indicated and our current marketing efforts are reaffirming that for us, really exciting to see that.
Matt Hewitt: That’s great. And maybe – and I realize maybe not specific, but how should we be thinking about the ASPs on the sequencing and maybe the margin profile on those? I would imagine that they’re – especially once you start to scale up, but I would imagine those could be some of the best margins in your portfolio, but any color there would be helpful/
Tracy Curley: Yes. Go back at margins are better than our core business.
Eric Langlois: Yes. The structure of the program has been the most interesting part, and that’s kind of part of the value proposition that we’ve really been communicating to our customer base that is truly a collaborative effort, right? I mean our suppliers are agreeing to us to access this material at little to no cost upfront. We’re able to share with them on the back end. So it’s really a collaboration in that sense. And then certainly, with the sequencing partners, we feel like we’re getting certainly commercial quality because we’re using a commercial partner, but we’re getting a pretty good value there. So overall, when we sell and market these samples to the market, as Tracy said, the margins are some of the best that we have and they’re only going to improve over time.